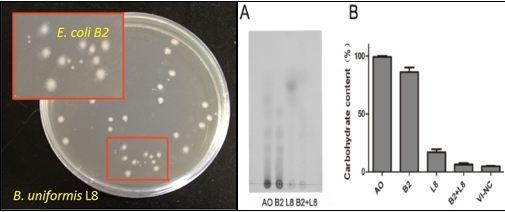

人体肠道微生物及其代谢产物与人类许多疾病的发生和发展密切相关,并从营养及免疫诸多环节预防疾病发生并保障人体健康。琼胶(Agar)是海洋红藻来源的具有凝胶特性的中性多糖,虽然早在一千多年前我国就从石花菜中用水提取琼胶作为健康食品,但是该多糖在中国人肠道中发生怎样的变化以及为何有利于人体健康一直缺乏有力的证据。
我院博士研究生李苗苗,在导师于广利教授和浙江农业科学院王欣研究员的共同指导下,经过3年多的研究,首次从人体肠道微生物中分离获得了一株可以降解琼胶及其寡糖的单形拟杆菌B. uniformis L8,并且发现该菌在降解琼胶过程中存在与大肠杆菌E. coli B2交互共生现象,前者将琼胶降解为寡糖和半乳糖,后者则利用前者所产生的半乳糖为营养, 琼胶及其寡糖作为功效因子有力促进了二个个共生菌的生长。这是首次有关中国人肠道微生物可以直接对琼胶降解的报道,为进一步研究海洋多糖和寡糖与肠道微生物的关系及其对人体健康的影响提供了新研究思路。这项成果发表在2014年3月12日PLos one上。
http://www.plosone.org/article/info%3Adoi%2F10.1371%2Fjournal.pone.0091106
【关闭】





